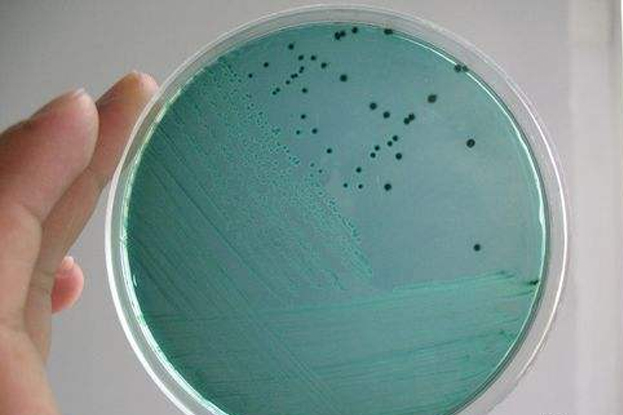
微生物污染的测试、法规等包括哪些产品

美国FDA认证标准是什么 一、FDA是指什么意思 FDA是食品和药物管理局(Food and Drug Administration)的简称,在中国,因为其标准比较高,因此多以美国FDA为准
微生物测试评估(Microbiological Test)的微生物指标主要包括:细菌总数、霉菌和酵母、绿脓杆菌、金黄色葡萄球菌、大肠杆菌、沙门氏菌、白色念珠菌、梭状芽孢杆菌、肠杆菌属及革兰氏阴性菌和胆

沙特SASO认证服务中心,为你全方位了解沙特新的标准法规,避免不需要的经济损失,还有沙特新的经济资讯,为开拓沙特市场提供参考依据,全方位介绍沙特SASO认证的认证流程,认证资料准备,认证周期,认证费用
